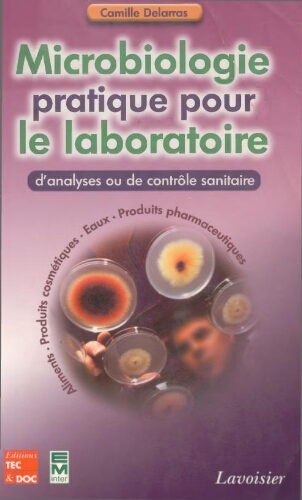
Microbiologie pratique pour le laboratoire d'analyses ou de contrôle sanitaire Microbiologie pratique pour le laboratoire d'analyses ou de contrôle sanitaire

Permalien :
Microbiologie pratique pour le laboratoire d'analyses ou de contrôle sanitaire
- Date_TXT
- Paris : Tec et Doc , 2007
- Cote
- 579.1 DEL
- Auteur
- Delarras, Camille
- Type de document
- Livre
Description :
Microbiologie pratique pour le laboratoire d'analyses ou de contrôle sanitaire concilie la théorie et la pratique grâce à sa conception originale en deux parties :
la première partie présente tout ce qu'il faut savoir pour équiper et conduire un laboratoire aujourd'hui : conception, fonctionnement, sécurité, réglementation, matériel, milieux de cultures classiques, chromogéniques..., méthodes de travail, d'isolement et d'identification des bactéries...
la deuxième partie traite de microbiologie appliquée et expose les méthodes d'analyse et de contrôle des principaux micro-organismes (dans les eaux, les aliments, les produits cosmétiques et pharmaceutiques...) : habitats, classifications, caractères principaux et/ou spécifiques, isolement avec milieux de culture récents, identification sur galeries api®, surveillance, épidémiologie.

 French
French